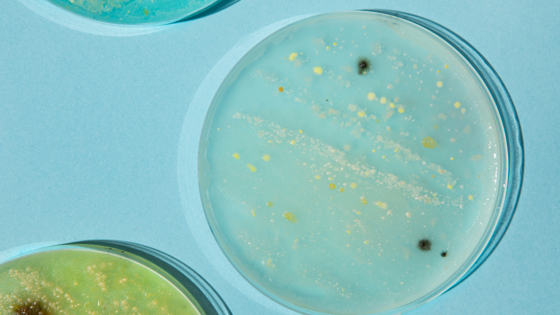

Новое исследование Медицинской школы Перельмана показало, что бактерия Alcaligenes faecalis (A. faecalis) может способствовать заживлению трудноизлечимых ран у людей с диабетом. Эти результаты могут помочь ученым в поиске новых методов лечения диабетических ран.
Ранее команда уже проводила исследования, изучая бактерии, которые обнаруживаются в язвах диабетической стопы с течением времени, и то, как они влияют на процесс заживления. Тогда было сделано открытие, что бактерия A. Faecalis способствует заживлению ран – и учёные запланировали дальнейшее ее изучение.
Для выявления механизма работы A. Faecalis ученые провели несколько тестов с мышами-диабетиками, их клетками кожи и образцами клеток кожи людей, страдающих диабетом. Они обнаружили, что использование A. Faecalis для инокуляции мышей-диабетиков с дефектами заживления ран, привело к ускоренному заживлению ран без признаков инфекции. Затем они увидели, что введение этой бактерии в раны приводит к тому, что кератиноциты, доминирующий тип ранозаживляющих клеток в эпидермисе, размножаются, увеличивают объем ткани и мигрируют, чтобы закрыть рану в большей степени, чем необработанные клетки. Образцы кожи, взятые у людей-диабетиков, были культивированы с A. faecalis, и через десять дней в образцах с бактерией наблюдался статистически значимо больший рост кератиноцитов.
Далее ученые выявили, что у мышей с диабетическими ранами, обработанными A. faecalis, обнаружились гены, связанные с активацией лейкоцитов, включая Т-клетки, которые важны для защиты иммунной системы. Бактерия также подавляет регуляцию генов, ответственных за распад коллагена, в частности ферментов, называемых матриксными металлопротеиназами (MMPs). При том, что у людей с диабетом слишком много ММП, которые препятствуют нормальному заживлению ран.
«Наши результаты показывают, что A. faecalis восстанавливает баланс экспрессии MMP в ранах, что позволяет быстрее их закрыть. В будущих исследованиях мы надеемся узнать больше о том, как бактерии взаимодействуют с клетками кожи, а также о том, как A. faecalis взаимодействует с другими бактериями в ране», – передает medicalXpress слова ученых.